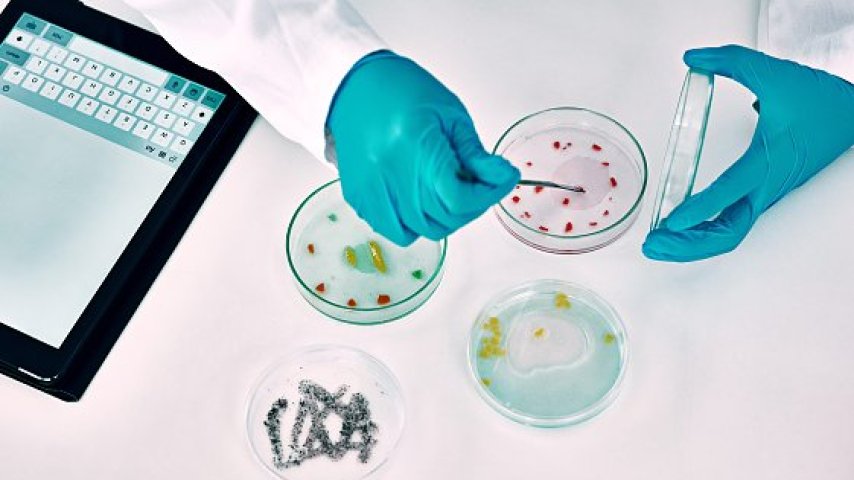

Bakterie jelitowe zmniejszają ryzyko rozwoju choroby wieńcowej
Naukowcy zidentyfikowali dziewięć produkowanych przez jelitowe bakterie substancji, które przenikają do krwi i wpływają na ryzyko choroby wieńcowej. Odkrycie może pomóc w profilaktyce i pracach nad nowymi terapiami.
Układ pokarmowy człowieka zawiera ogromną populację różnorodnych mikroorganizmów. Naukowcy z Vanderbilt University wskazali sposób, w jaki część z tych mikrobów wpływa na zdrowie serca.
Przeprowadzili analizę próbek krwi pochodzących łącznie od kilku tysięcy dorosłych osób – czarnoskórych, rasy białej i pochodzenia azjatyckiego, z różnych regionów Stanów Zjednoczonych i z Szanghaju. Analiza pokazała obecność dziewięciu metabolitów pochodzących od mikroorganizmów jelitowych, które były związane z większym lub mniejszym prawdopodobieństwem rozwoju choroby wieńcowej. Warto zaznaczyć, że pewne różnice w związkach między poszczególnymi metabolitami a ryzykiem choroby serca pojawiły się, gdy badanych podzielono według rasy lub wieku.
Naukowcy apelują o dalsze badania nad zidentyfikowanymi metabolitami, aby ustalić, czy mogą one stanowić obiecujące kierunki rozwoju nowych metod leczenia lub zapobiegania chorobie wieńcowej.
– To jedno z najbardziej kompleksowych, przeprowadzonych jak dotąd badań z zakresu metabolomiki, obejmujące etap samego odkrycia, walidację in silico oraz walidację ilościową prowadzoną u osób z różnych grup etnicznych i regionów geograficznych – stwierdzili autorzy pracy opublikowanej w magazynie „PLOS Medicine”.
– Nasze wyniki podkreślają znaczenie metabolizmu mikroorganizmów jelitowych w rozwoju chorób układu sercowo-naczyniowego oraz wskazują obiecujące cząsteczki, które w przyszłości mogą służyć jako nowe biomarkery lub cele terapeutyczne w badaniach mechanistycznych i interwencyjnych – podkreślili.






